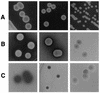
FIG. 2

Microevolution of a standard strain of Cryptococcus neoformans resulting in differences in virulence and other phenotypes
- PMID: 9423844
- PMCID: PMC107863
- DOI: 10.1128/IAI.66.1.89-97.1998
Microevolution of a standard strain of Cryptococcus neoformans resulting in differences in virulence and other phenotypes
Abstract
Cryptococcus neoformans is a major fungal pathogen for patients with debilitated immune systems. However, no information is available on the stability of virulence or of phenotypes associated with virulence for C. neoformans laboratory strains. A serendipitous observation in our laboratory that one isolate of C. neoformans ATCC 24067 (strain 52D) became attenuated after continuous in vitro culture prompted us to perform a comparative study of nine strain 24067 isolates obtained from six different research laboratories. Each isolate was characterized by DNA typing, virulence for mice, proteinase production, extracellular protein synthesis, melanin synthesis, carbon assimilation pattern, antifungal drug susceptibility, colony morphology, growth rate, agglutination titers, phagocytosis by murine macrophages, capsule size, and capsular polysaccharide structure. All isolates had similar DNA typing patterns consistent with their assignment to the same strain, although minor chromosome size polymorphisms were observed in the electrophoretic karyotypes of two isolates. Several isolates had major differences in phenotypes that may be associated with virulence, including growth rate, capsule size, proteinase production, and melanization. These findings imply that C. neoformans is able to undergo rapid changes in vitro, probably as a result of adaptation to laboratory conditions, and suggest the need for careful attention to storage and maintenance conditions. In summary, our results indicate that C. neoformans (i) can become attenuated by in vitro culture and (ii) is capable of microevolution in vitro with the emergence of variants exhibiting new genotypic and phenotypic characteristics.
Figures

References
-
- Brandt M E, Pfaller M A, Hajjeh R A, Graviss E A, Ress J, Spitzer E D, Pinner R W, Mayer L W the Cryptococcal Disease Active Surveillance Group. Molecular subtypes and antifungal susceptibilities of serial Cryptococcus neoformans isolates in human immunodeficiency virus-associated cryptococcosis. J Infect Dis. 1996;174:812–820. - PubMed
Publication types
MeSH terms
Substances
Grants and funding
LinkOut - more resources
Full Text Sources

